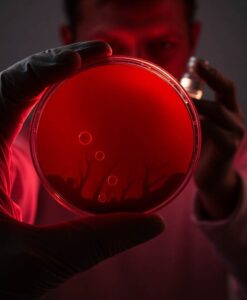
How type 2 diabetes quietly damages blood vessels - AI Generated Image

Researchers tracked changes inside red blood cells and found that a specific small molecule shifts as diabetes progresses. That molecular change appears to interfere with signals that keep blood vessels flexible. If those early changes can be detected, clinicians might identify people whose cardiovascular risk is climbing long before symptoms appear.
Understanding these early, hidden steps matters for keeping people healthy and active. If a simple blood test could reveal when a person’s vascular system is starting to fail, doctors could tailor treatments to protect the heart and preserve quality of life. Follow the full article to see how this molecular clue connects to prevention, therapy, and more inclusive approaches to long-term care.
Type 2 diabetes becomes more dangerous to the heart the longer a person has it. Researchers found that after several years, red blood cells can begin interfering with healthy blood vessel function. This harmful shift was not present in newly diagnosed patients but emerged over time. A small molecule inside blood cells may help flag rising cardiovascular risk early.